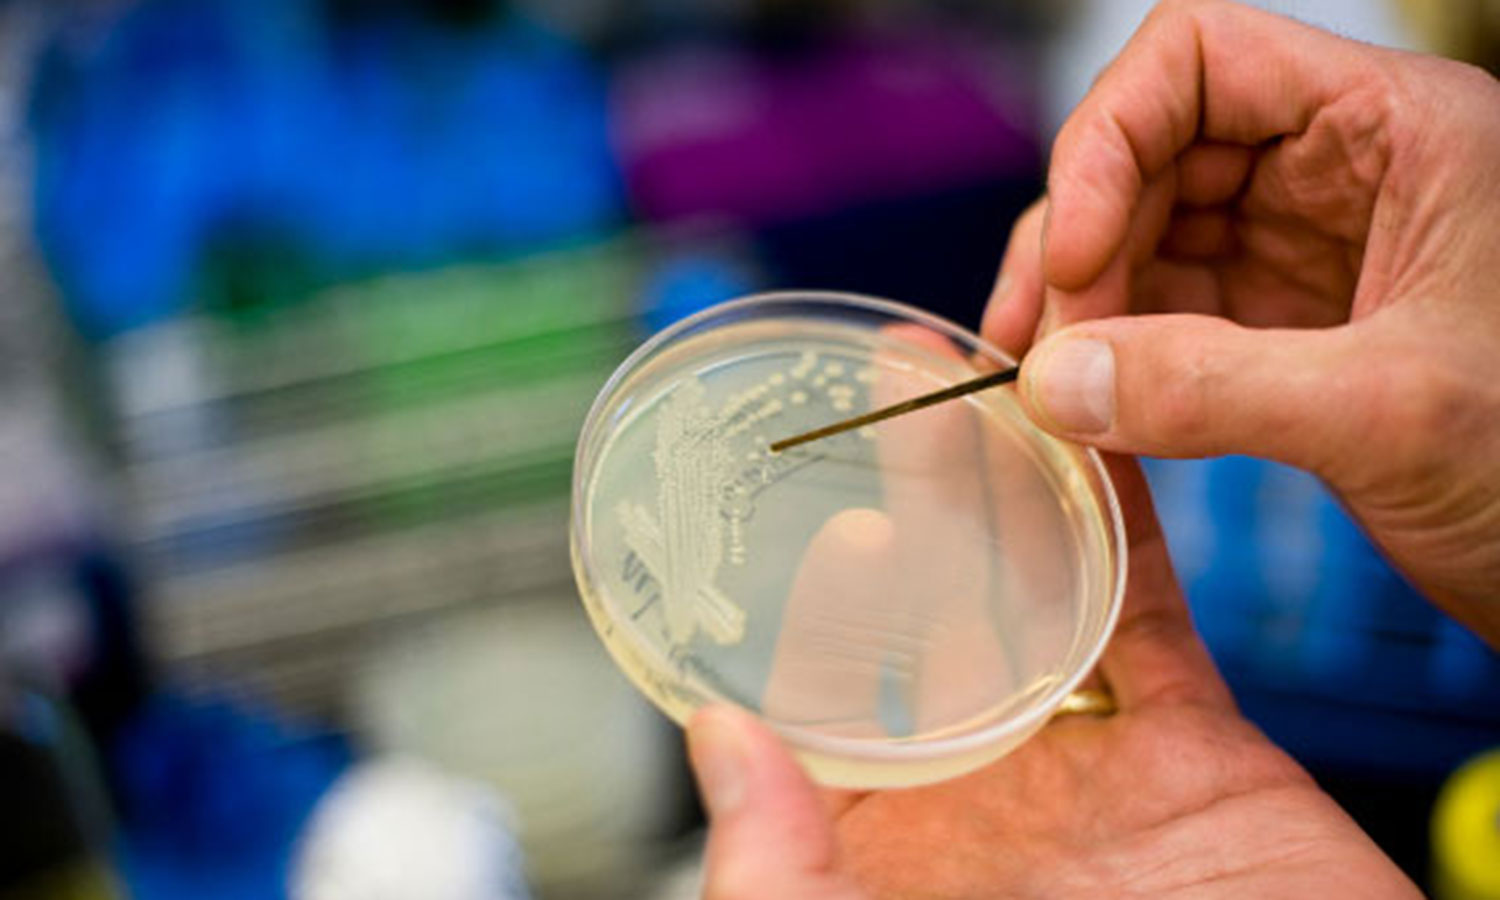

என் மலர்
இந்தியா
இந்தியாவில் ஒரே ஆண்டில் 7 லட்சம் பேர் உயிரைப்பறித்த 5 வகை பாக்டீரியா: அதிர்ச்சி தகவல்கள்
- உலக அளவில் அதிக இறப்புகளை ஏற்படுத்திய பாக்டீரியா, எஸ். ஆரியஸ் ஆகும்.
- எஸ். ஆரியஸ் பாக்டீரியாவால் 11 லட்சம் பேர் இறந்துள்ளனர்.
புதுடெல்லி :
உலகமெங்கும் 2019-ம் ஆண்டில் 77 லட்சம் பேர் 33 வகையான பொதுவான பாக்டீரியா தொற்றினால் மரணத்தைத் தழுவி உள்ளனர். இவற்றில் 50 சதவீதத்துக்கும் (54.2 சதவீதம்) மேலான உயிரிழப்புகளுக்கு 5 பாக்டீரியாக்கள் மட்டுமே காரணம் ஆகும். அந்த பாக்டீரியாக்கள் இ.கோலி, எஸ்.நிமோனியா, கே.நிமோனியா, எஸ்.ஆரியஸ் மற்றும் ஏ.பவுமனி ஆகியவைதான்.
இந்த பாக்டீரியாக்கள் இந்தியாவில் மட்டும் 2019-ம் ஆண்டில் 6 லட்சத்து 80 பேரின் உயிர்களைப் பறித்துள்ளன.
இந்த ஆய்வுத்தகவல்களை இங்கிலாந்தில் இருந்து வெளிவரும் ' தி லேன்செட்' மருத்துவப் பத்திரிகை வெளியிட்டுள்ளது.
இதில் வெளியாகி உள்ள கூடுதல் தகவல்கள் வருமாறு:-
* ஆராய்ச்சியாளர்கள் நடத்தியுள்ள புதிய ஆய்வு 33 பொதுவான பாக்டீரியா மற்றும் 11 முக்கிய தொற்று வகைகளுடன் தொடர்புடைய இறப்பு பற்றிய முதல் உலகளாவிய மதிப்பீடுகளை வழங்கி உள்ளது.
* இ.கோலி என்ற மிகக்கொடிய பாக்டீரியா மட்டும் இந்தியாவில் 2019-ல் 1 லட்சத்து 57 ஆயிரத்து 82 பேரின் உயிரிழப்புக்கு காரணமாகி உள்ளது.
* 2019-ம் ஆண்டில் உலகளவில் நிகழ்ந்த இறப்புகளில் முக்கிய காரணியாக 'இஸ்கிமிக்' இதய நோய்க்கு அடுத்த படியாக இந்த பாக்டீரியா தொற்றுகள் இரண்டாவது இடத்தில் உள்ளன. இந்த பாக்டீரியாக்களால் ஏற்படுகிற உயிரிழப்புகளை குறைக்க வேண்டியதின் அவசியத்தை இது எடுத்துக்காட்டுகிறது.
* உலக அளவில் அதிக இறப்புகளை ஏற்படுத்திய பாக்டீரியா, எஸ். ஆரியஸ் ஆகும். இந்த பாக்டீரியாவால் 11 லட்சம் பேர் இறந்துள்ளனர். இந்த பாக்டீரியா 15 ஆண்டுகளாக 15 வயதுக்கு மேற்பட்டோரை பலி கொண்டு வந்திருக்கிறது.
* ஆப்பிரிக்க நாடுகளில் இந்த பாக்டீரியா இறப்பு விகிதம், 1 லட்சத்துக்கு 230 என்ற அளவில் உள்ளது. மிகக்குறைந்த இறப்புகள் என்றால் அது மேற்கு ஐரோப்பா, வட அமெரிக்கா, ஆஸ்திரேலேசியா (ஆஸ்திரேலியா-நியூசிலாந்து) ஆகியவற்றில்தான் நேர்ந்துள்ளது. இங்கு 1 லட்சம் பேரில் 52 பேர் இறப்பு பதிவாகி உள்ளது.
இந்த ஆராய்ச்சி முடிவுகள் குறித்து ஆராய்ச்சியாளர் கிறிஸ்டோபர் முர்ரே கூறுகையில், "பாக்டீரியா தொற்றுகள், உலகளாவிய சுகாதார நெருக்கடியாக மாறி இருக்கிறது என்பதை முதல் முறையாக இந்த புதிய தரவுகள் காட்டுகின்றன. இந்த முடிவுகளை உலகளாவிய சுகாதார நடவடிக்கைகளின் ரேடாரில் வைப்பது மிகவும் முக்கியமானது. இதனால் இந்த கொடிய தொற்றுநோய்களினால் பாதிக்கப்படுவோரின் எண்ணிக்கையை குறைக்கவும், இறப்புகளை குறைத்திடவும் முதலீடுகள் செய்யப்படுகின்றன" என தெரிவித்தார்.









